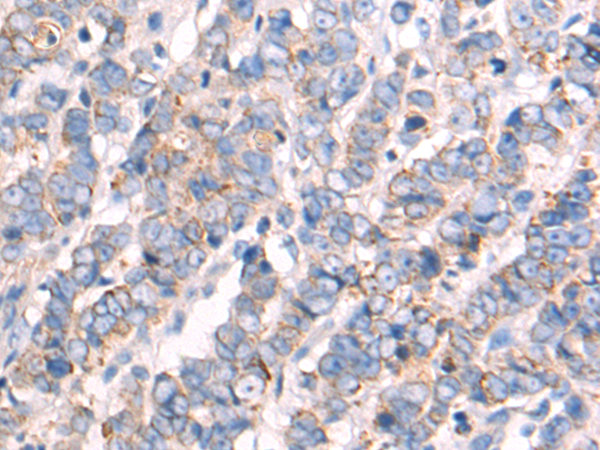
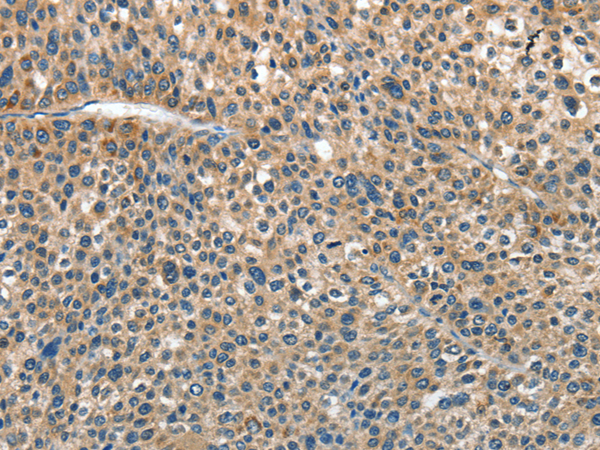
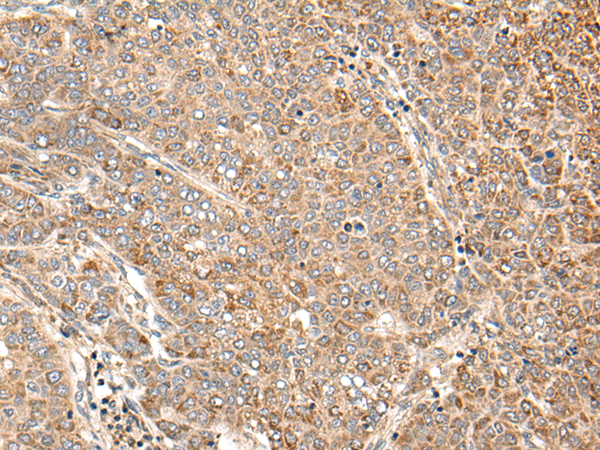

-
分类: 科研抗体货号: P07052别名: P80; IL1R; IL1RA; CD121A; D2S1473; IL-1R-alpha应用: IHC反应种属: Human, Mouse
-
分类: 科研抗体货号: P07082别名: ANX4; PIG28; ZAP36应用: WB,IHC反应种属: Human, Mouse, Rat
-
分类: 科研抗体货号: P07081别名: ANX1; LPC1应用: WB反应种属: Human, Mouse, Rat
-
分类: 科研抗体货号: P07069别名: AIF; AUNX1; CMT2D; CMTX4; COWCK; DFNX5; NADMR; NAMSD; PDCD8; COXPD6; SEMDHL应用: WB,IHC反应种属: Human, Mouse, Rat
-
分类: 科研抗体货号: P07079别名: AGP1; AGPT; ANG1应用: WB,IHC反应种属: Human, Mouse, Rat
-
分类: 科研抗体货号: P07068别名: AT1; AG2S; AT1B; AT1R; AT1AR; AT1BR; AT2R1; HAT1R; AGTR1B应用: WB反应种属: Human, Mouse, Rat
-
分类: 科研抗体货号: P07077别名: ANL3; ANG-5; FHBL2; ANGPT5应用: WB,IHC反应种属: Human
-
分类: 科研抗体货号: P07099别名: APJ; APJR; HG11; AGTRL1应用: IHC反应种属: Human, Mouse, Rat
-
分类: 科研抗体货号: P07076别名: NL2, ARP4, FIAF, PGAR, HFARP, pp1158, ANGPTL2应用: IHC反应种属: Human
-
分类: 科研抗体货号: P07098别名: OI4; EDSCV; EDSARTH2应用: IHC反应种属: Human, Mouse, Rat

鄂公网安备42018502007531号
鄂公网安备42018502007531号

